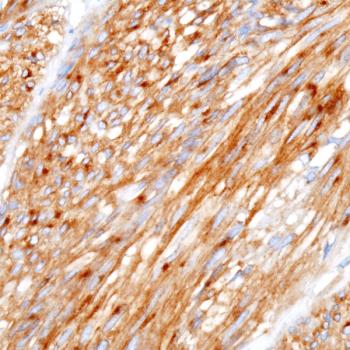

The triplet regimen also improved health-related quality of life and pain compared with ADT plus ARPI alone in patients with metastatic hormone-sensitive prostate cancer.

Your AI-Trained Oncology Knowledge Connection!


The triplet regimen also improved health-related quality of life and pain compared with ADT plus ARPI alone in patients with metastatic hormone-sensitive prostate cancer.

Results from the PEACE-3 trial found an extended OS after patients with metastatic castration-resistant prostate cancer were treated with enzalutamide/radium-223.

Data from the CAPItello-281 trial may support capivasertib/abiraterone as a first-in-class targeted therapy in this metastatic hormone-sensitive prostate cancer population.

Data from the PREFER study may provide evidence for improving oncofertility counseling for premenopausal women with early breast cancer.

Nuvisertib combined with momelotinib achieved a spleen volume reduction of 25% at week 24 and any given time in 50% of patients with relapsed/refractory myelofibrosis.

Findings from the ENZARAD trial support adding enzalutamide to androgen deprivation therapy for those with positive lymph nodes.

Data from a propensity-matched analysis showed that GLP-1 receptor agonists conferred benefits even among patients with type 2 diabetes.

Investigators are currently assessing possible predictors for response to inavolisib as part of the phase 2 CRAFT trial.

Data from a phase 1b/2 trial show that sonrotoclax/dexamethasone appears to be well tolerated in a heavily pretreated multiple myeloma population.
Olverembatinib has shown promising clinical efficacy in SDH-deficient gastrointestinal stromal tumors, says Haibo Qiu, MD.

Isatuximab, bortezomib, lenalidomide, and dexamethasone prolonged PFS vs bortezomib, lenalidomide, and dexamethasone, in a subsect of patients with multiple myeloma.

The median progression-free survival and overall survival was extended with rivoceranib among those with unresectable HCC in the CARES-310 trial.

Relapse-free survival was improved when anthracycline combo was used to treat MammaPrint high-2–risk, BluePrint Luminal B, HR-positive, HER2-negative breast cancer.

Findings from the phase 2 RAMP 201 trial highlight responses with avutometinib/defactinib in those with KRAS-mutated low-grade serous ovarian cancer and other patient subgroups.

Testing for HRR status prior to a diagnosis of metastatic castration-resistant prostate cancer may allow for earlier treatment and potentially greater clinical benefit with olaparib, according to Daniel J. George, MD.

Latin American patients appear more likely to be diagnosed with aggressive early-stage breast cancer based on factors including metabolics and genetics, according to findings from the FLEX study.

Treatment with EX103 produces deep responses among heavily pretreated patients with B-cell non-Hodgkin lymphoma across multiple subgroups in a phase 1 trial.

Trastuzumab deruxtecan produces enduring responses among patients with HER2-mutated solid tumors in the phase 2 DESTINY-PanTumor01 trial.

Pembrolizumab appears to improve overall survival vs placebo when added to trastuzumab and chemotherapy among patients with metastatic HER2-positive gastric or gastroesophageal junction cancer.

Investigators of the phase 1b/2 KontRASt-01 trial will continue their evaluation of TNO155 plus JDQ433 in KRAS G12C-mutated solid tumors as part of an expansion portion of the trial.

Baseline characteristics do not appear to correlate with long-term benefits for patients receiving durvalumab plus tremelimumab and chemotherapy for metastatic non–small cell lung cancer in the phase 3 POSEIDON trial.

Zanubrutinib and acalabrutinib produce similar safety profiles in the treatment of patients with relapsed/refractory chronic lymphocytic leukemia in the phase 3 ASCEND and APLINE trials.

BL-B01D1 may produce promising antitumor activity in a heavily pretreated population of patients with EGFR-mutated non–small cell lung cancer, according to an expert at University Cancer Center in Guangzhou, China.

Fruquintinib plus best supportive care elicits a progression-free survival benefit across all prior treatment subgroups among patients with refractory metastatic colorectal cancer in the phase 3 FRESCO-2 trial.

GCF012F may show promising activity in relapsed and refractory multiple myeloma, according to an expert from Shanghai Chang Zheng Hospital.

A retrospective study clarifies how the implementation of avelumab maintenance looks in real-world practice, according to an expert from Seattle Cancer Care Alliance.

Findings from a phase 2 trial indicate that CTX-009 plus paclitaxel may produce an encouraging responses in patients with advanced biliary tract cancer, according to investigators.

Those with chronic myeloid leukemia, Philadelphia chromosome-positive acute lymphoblastic leukemia, and those with CML whose tumors have a T315I mutation, were found to have improved efficacy when olverembatinib was given.

Non-Hispanic Black patients with HR+ breast cancer experienced worse overall outcomes compared with other patient subgroups despite similar recurrence scores, according to a recent analysis of the phase 3 RxPONDER trial.

In the phase 1b EQUATE trial, patients with acute graft-versus-host disease had decreased levels of cell-surface CD6 when treated with itolizumab.